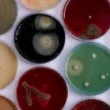

جدول المحتويات
- الأهمية الاقتصادية للغابات الاستوائية المطيرة
- إنتاج الأدوية من الغابات الاستوائية
- دور الغابات في تنقية الهواء
- توفير الغذاء من خلال الغابات
- المساهمة في توفير المياه
- أهمية وضع قوانين لحماية الغابات
الأهمية الاقتصادية للغابات الاستوائية المطيرة
تعتبر الغابات الاستوائية المطيرة من أكثر النظم البيئية أهمية على كوكب الأرض، ليس فقط بسبب تنوعها البيولوجي الفريد، ولكن أيضًا بسبب دورها الحيوي في الاقتصاد العالمي. هذه الغابات توفر العديد من الموارد الطبيعية التي تعتمد عليها الصناعات المختلفة، كما تساهم في الحفاظ على التوازن البيئي الذي يؤثر بشكل مباشر على حياة البشر.
إنتاج الأدوية من الغابات الاستوائية
تلعب الغابات الاستوائية المطيرة دورًا كبيرًا في صناعة الأدوية. تشير الدراسات إلى أن حوالي 25% من الأدوية المستخدمة عالميًا مصدرها نباتات تنمو في هذه الغابات. على سبيل المثال، دواء الفينكرستين (Vincristine)، المستخرج من نباتات وردية في مدغشقر، يستخدم لعلاج سرطان الدم بنسبة نجاح تصل إلى 80% في المراحل المبكرة. بالإضافة إلى ذلك، يستخدم سم الكورارا (Curare)، الذي يستخدمه السكان الأصليون في الصيد، كمرخٍ للعضلات عند استخدامه بجرعات صغيرة. ومع أن 1% فقط من نباتات هذه الغابات تمت دراستها، إلا أن النتائج تشير إلى إمكانية اكتشاف علاجات جديدة لأمراض مستعصية.
دور الغابات في تنقية الهواء
تُعرف الغابات الاستوائية المطيرة بأنها “رئة العالم”، حيث تساهم بنحو 20% من الأكسجين الموجود في الغلاف الجوي. تقوم النباتات بامتصاص ثاني أكسيد الكربون وإطلاق الأكسجين، مما يساعد في تقليل التلوث الناتج عن انبعاثات المصانع ووسائل النقل. في ظل التحديات البيئية الحالية، مثل تغير المناخ وارتفاع مستويات التلوث، تصبح هذه الغابات أكثر أهمية في الحفاظ على جودة الهواء.
توفير الغذاء من خلال الغابات
تحتوي الغابات الاستوائية المطيرة على مجموعة واسعة من النباتات التي توفر الغذاء للبشر والحيوانات. على سبيل المثال، ينتج نخيل الخوخ في البرازيل أكثر من 300 نوع من الفواكه الغنية بالعناصر الغذائية. هذه الفواكه تحتوي على ضعف القيمة الغذائية الموجودة في الموز، وتوفر كميات كبيرة من البروتين والكربوهيدرات. بالإضافة إلى ذلك، تعتمد أكثر من 1000 قبيلة تعيش في هذه الغابات على مواردها الطبيعية للبقاء على قيد الحياة، مما يجعلها مصدرًا حيويًا للغذاء.
المساهمة في توفير المياه
تلعب الغابات الاستوائية المطيرة دورًا رئيسيًا في دورة المياه الطبيعية. فهي تساعد في تخزين المياه الجوفية العذبة، والتي تعد مصدرًا مهمًا لمياه الشرب والري. على سبيل المثال، يحتوي حوض الأمازون وحده على حوالي 20% من المياه العذبة الموجودة على سطح الأرض. هذا يجعل الغابات الاستوائية مصدرًا لا غنى عنه للحفاظ على توازن المياه في العالم.
أهمية وضع قوانين لحماية الغابات
على الرغم من الفوائد الاقتصادية والبيئية الكبيرة للغابات الاستوائية المطيرة، إلا أنها تواجه تهديدات متزايدة بسبب الأنشطة البشرية مثل قطع الأشجار والتوسع الزراعي. يعتمد أكثر من مليار شخص في العالم على هذه الغابات لكسب رزقهم، مما يجعل حمايتها أمرًا ضروريًا. يجب على الحكومات والمنظمات الدولية وضع قوانين صارمة لمنع تدمير هذه الغابات والحفاظ على مواردها للأجيال القادمة.
المراجع
- “Why are Rainforests Important?”, ypte.org.uk, تم الاسترجاع في 22-1-2022.
- “Benefits of the Rainforest”, monq.com, تم الاسترجاع في 22-1-2022.
- “Tropical Rainforests: The 3 Benefits of Tropical Rainforests”, masterclass.com, تم الاسترجاع في 22-1-2022.